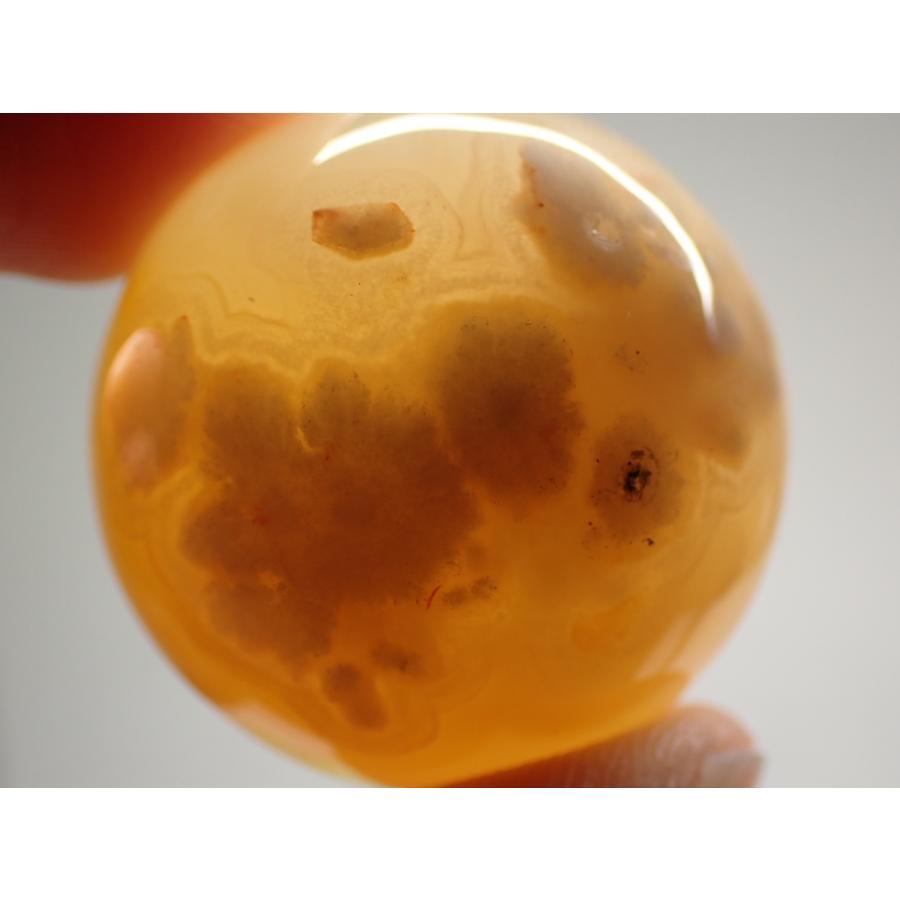

1/12
桜瑪瑙/Cherry Blossom Agate 丸玉 C-AGT030
¥2,200 税込
残り1点
なら 手数料無料で 月々¥730から
サイズ…28mm
重さ…29.6g
産地…Mahajanga,Madagascar(マダガスカル)
-
レビュー
(331)
-
送料・配送方法について
-
お支払い方法について
¥2,200 税込
最近チェックした商品
同じカテゴリの商品
セール中の商品
その他の商品
CATEGORY